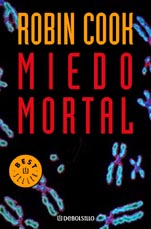
Descargar MIEDO MORTAL

Descargar TOXINA epub mobi pdf libro escrito por ROBIN COOK de la editorial DEBOLSILLO.
ISBN:9788497595087

Kim Reggis, un cirujano cardiovascular conocido, lleva a su hija Becky a cena típica hamburguesa con papas a la francesa es, sin imaginar que este evento diario van cambiar [...] Sigue leyendo